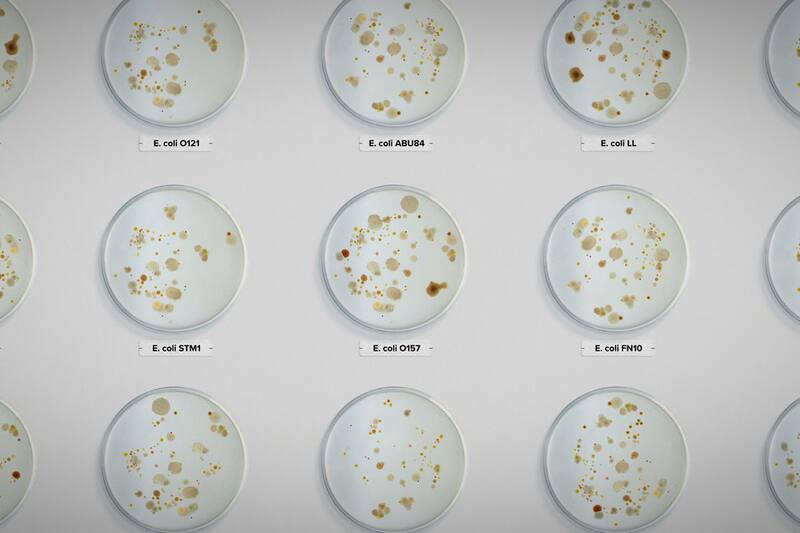

Intoxicación: la cruda verdad sobre nuestra comida, el revelador documental en torno a la industria alimentaria
La película revela la insalubre realidad acerca de la industria alimentaria en Estados Unidos, afectada por mortales casos de intoxicación por agentes patógenos.

A pesar de que el true crime domina su área documental, Netflix suma regularmente a su apartado de realidad piezas como Intoxicación: la cruda verdad sobre nuestra comida.
La cinta dirigida por Stephanie Soechtig (Fed up) que, como su extenso título expone, busca revelar la insalubre realidad en torno a la industria alimentaria en Estados Unidos.
La cual, sin lugar a dudas, debe replicarse en muchos países alrededor del planeta, que ni siquiera se exhiben como la nación con “el suministro de alimentos más seguro del mundo".

Intoxicación: la cruda verdad sobre nuestra comida | Netflix
Una última denominación con que las figuras políticas y comerciales estadounidenses definen a su cadena alimentaria, pero que está lejos de ser real como lo expone este documental.
El que se basa en el libro Poisoned, de Jeff Benedict, y tiene como uno de sus hilos conductores a Bill Marler, abogado que al inicio del relato aborda el riesgo de los alimentos crudos.
Como la fruta cortada y lechuga romana que se compran en los supermercados pensando que son más saludables. Sin embargo, los millones de enfermos por su causa descubrieron lo contrario.
Los agentes patógenos que enferman a miles
Intoxicación: la cruda verdad sobre nuestra comida | Netflix
Pero también Marler fue testigo directo de cómo también los alimentos procesados son causantes de enfermedad y muerte, tal como en 1993 con el brote de E. coli en el estado de Washington.
Cuando el abogado representó a varias víctimas del accionar de esa bacteria, luego de que llegará a muchos consumidores a través de las hamburguesas de la cadena Jack in the Box.
En el inicio de una carrera que lo ha llevado a ser testigo y activista frente a diferentes casos de contaminación y enfermedad dentro de la industria alimentaria en EE.UU.

Intoxicación: la cruda verdad sobre nuestra comida | Netflix
Entre los cuales el documental expone el de los patógenos hallados en lechugas y espinacas debido a excrementos de animales en los canales de irrigación en las zonas de cultivo.
Como también a la existencia de salmonela en los pollos, algo que todavía no puede ser controlado totalmente, o de esta misma bacteria en una productora de maní hace algunos años.
Muchos incidentes ante los cuales legisladores y representantes gubernamentales no han respondido adecuadamente, varias veces presionados por los representantes de las industrias.
Lo que se conoce en una narración ágil y bien documentada, donde son claves las opiniones de expertos y de los afectados por la negligencia de productores y agencias del gobierno.
COMENTARIOS
Para comentar este artículo debes ser suscriptor.
Lo Último
Lo más leído
Plan digital + LT Beneficios por 3 meses
Comienza el año bien informado y con beneficios para ti ⭐️$3.990/mes SUSCRÍBETE













